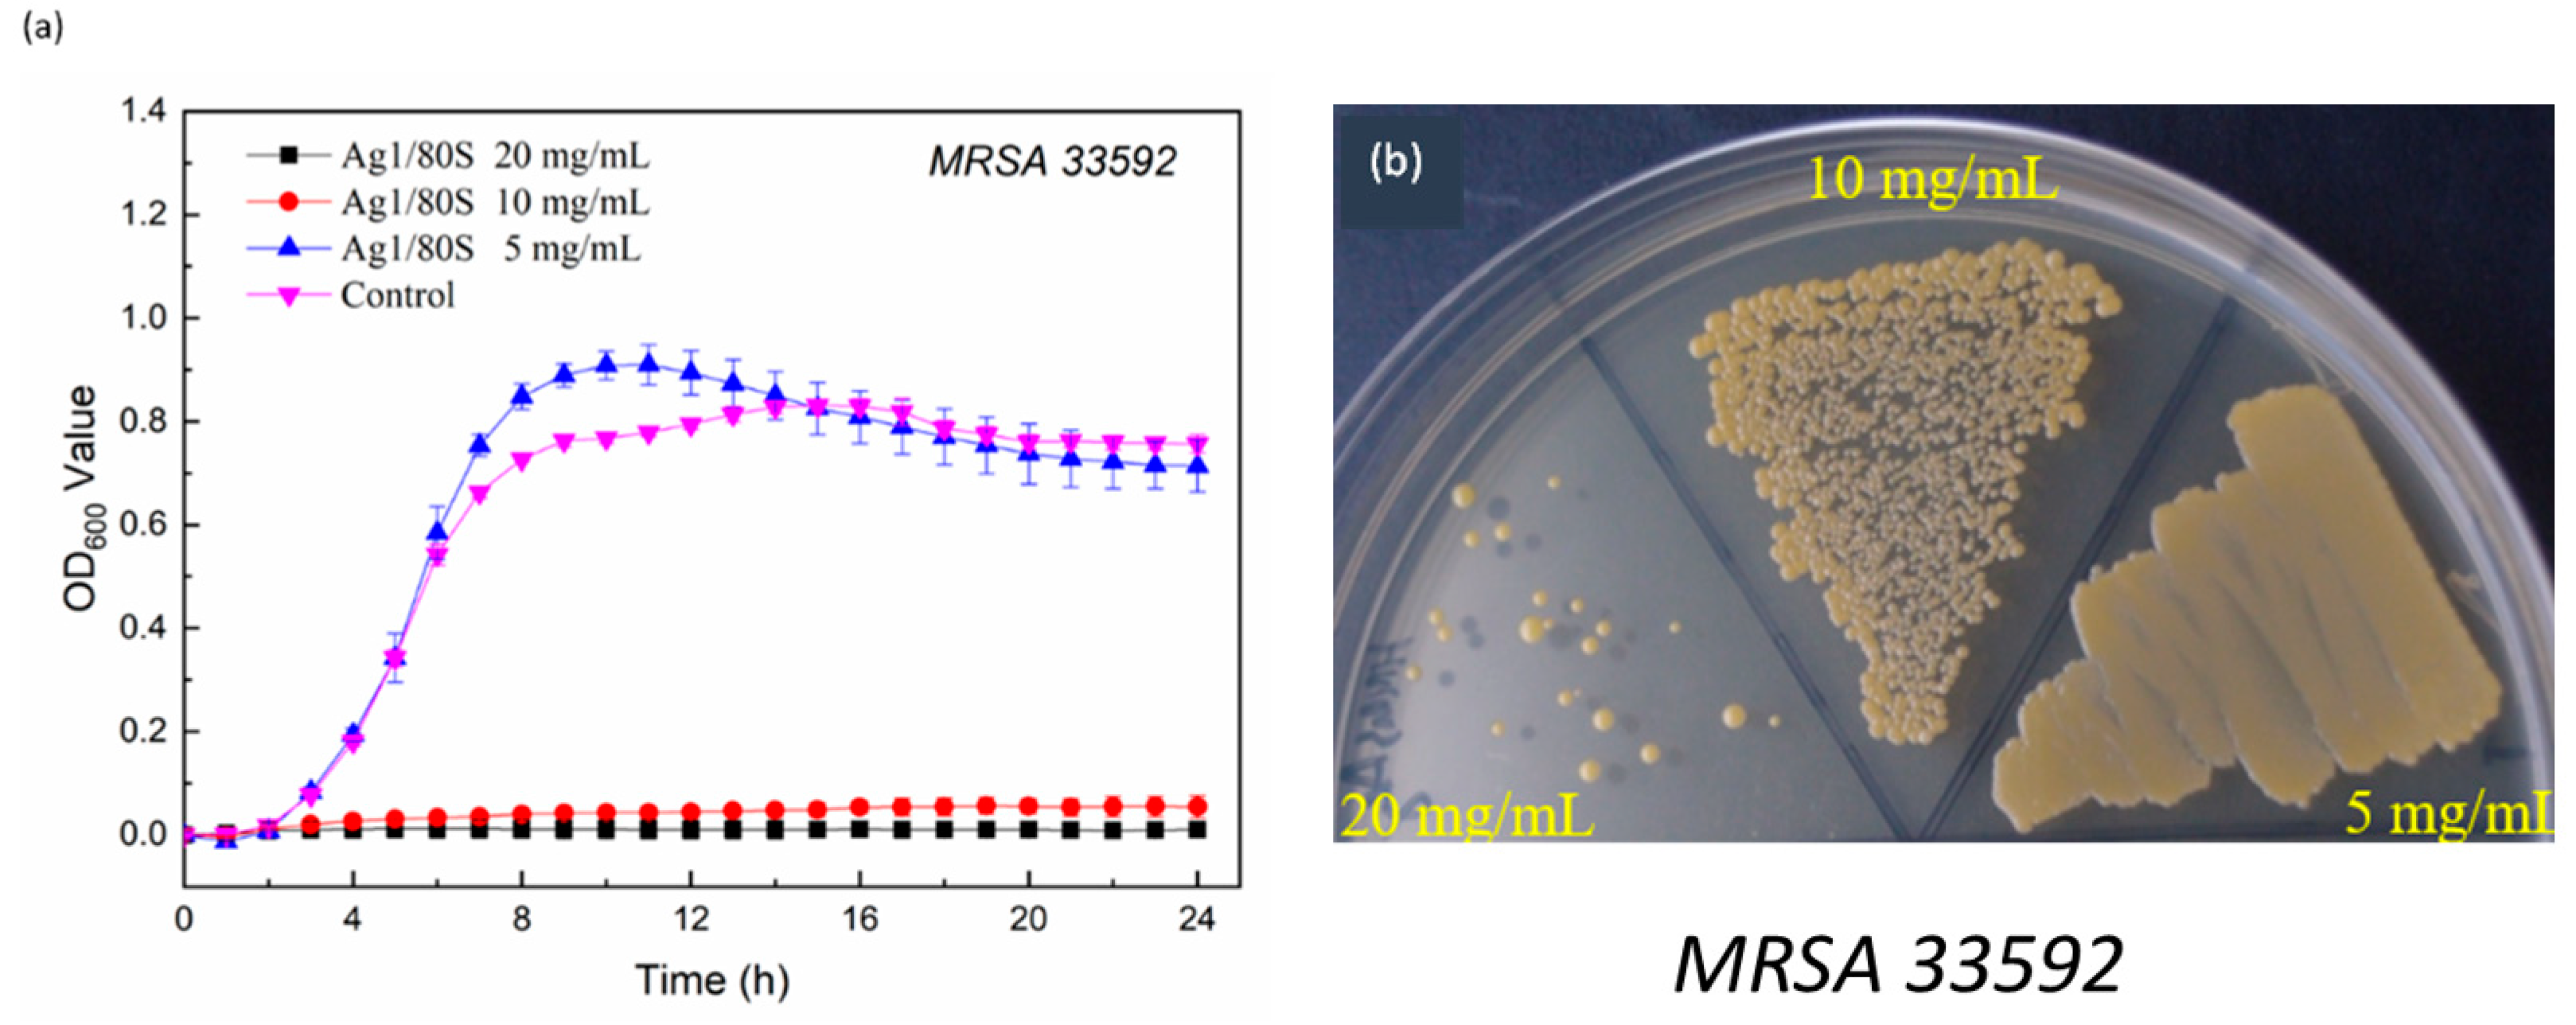
Nanomaterials 10 01264 g009 Nanomaterials 10 01264 g009
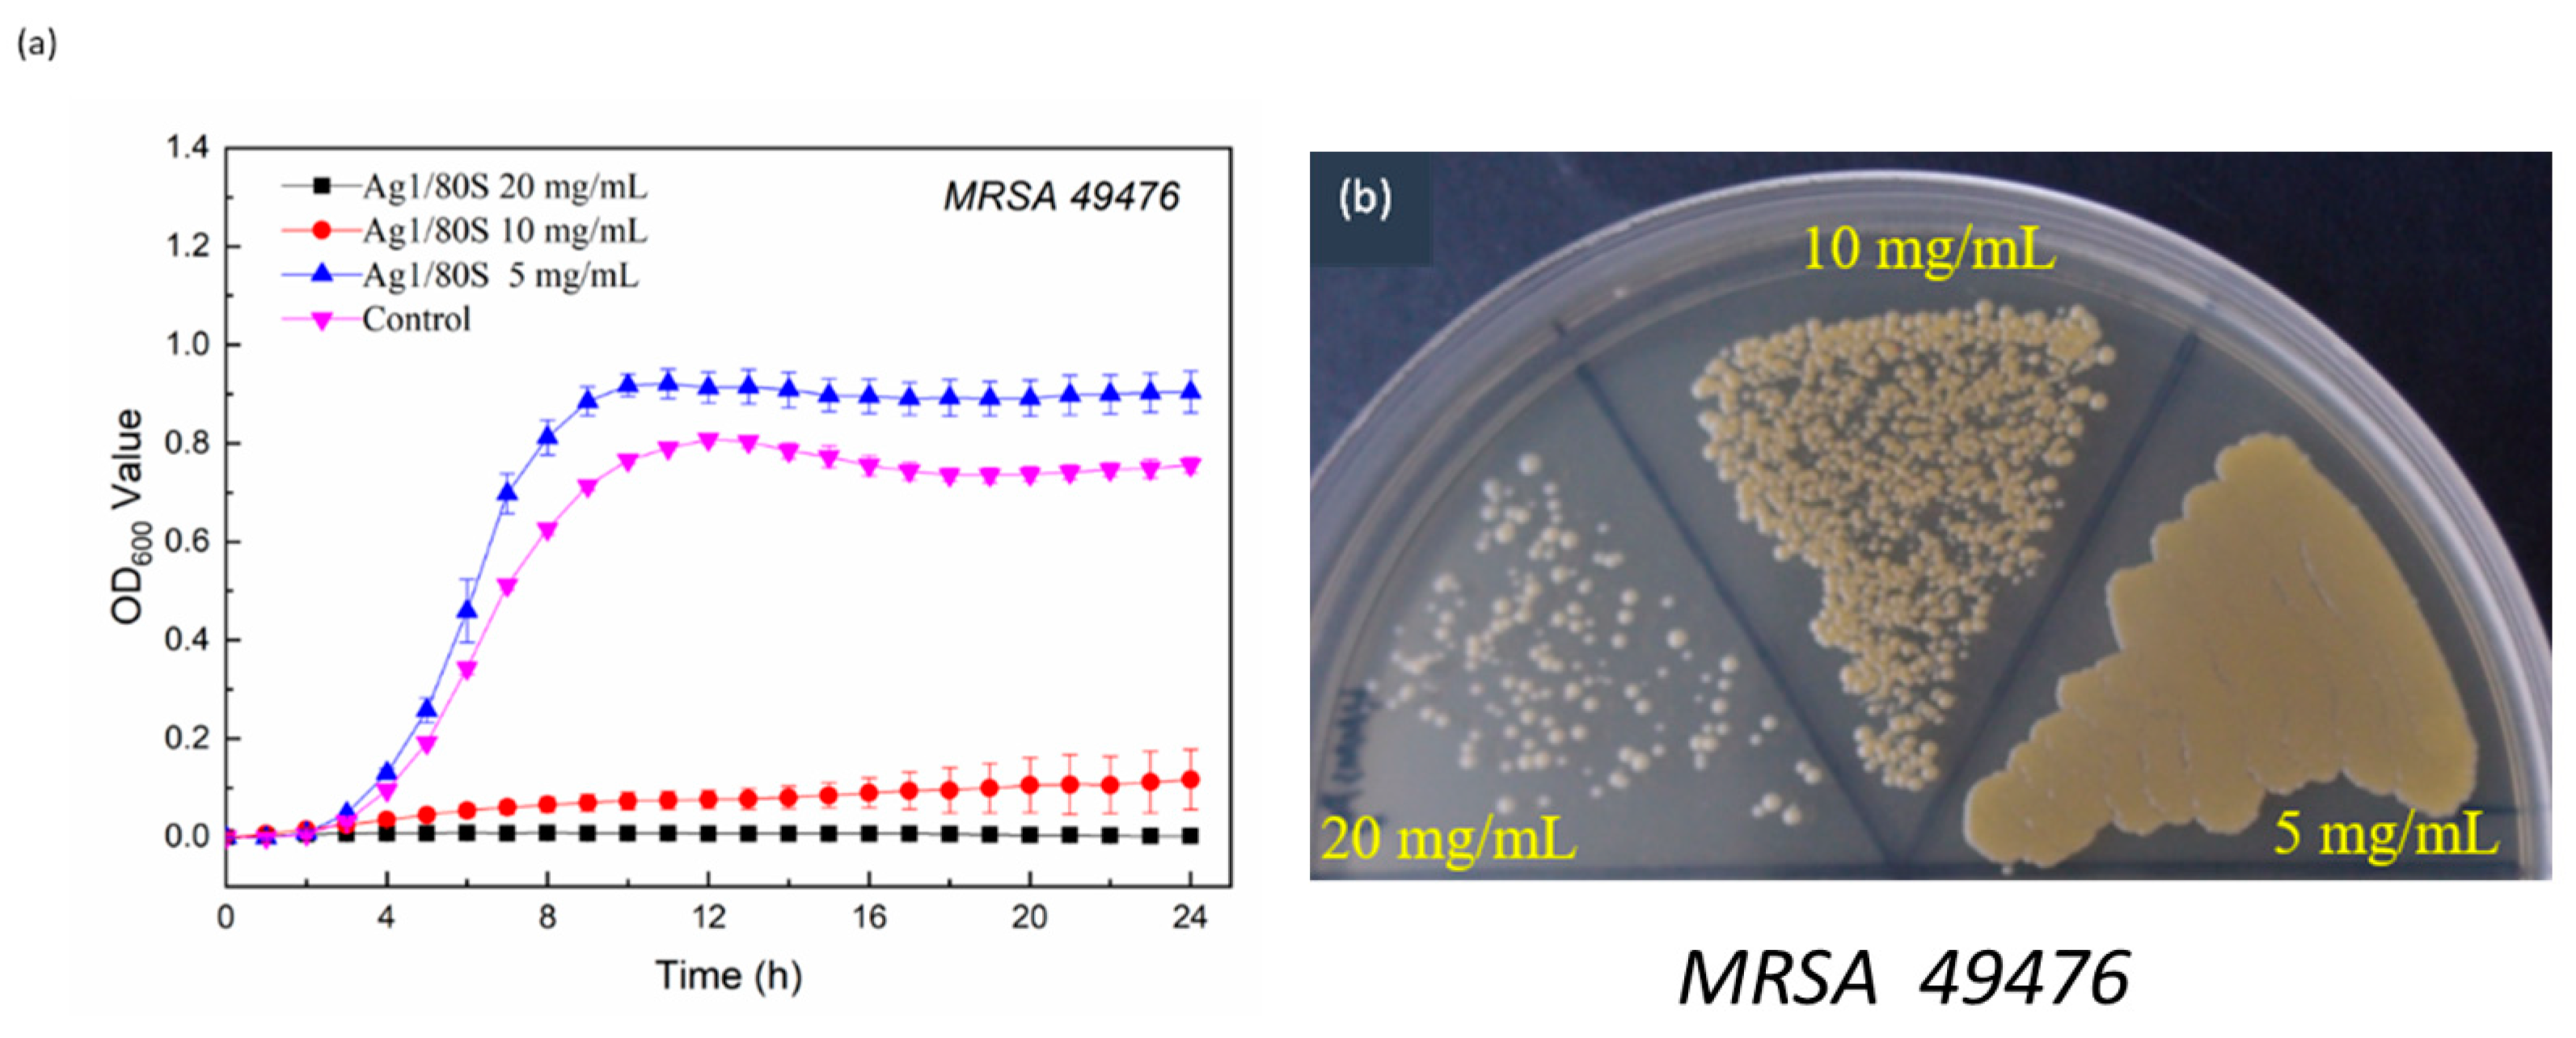
Nanomaterials 10 01264 g010 Nanomaterials 10 01264 g010

Antibacterial Activity of Silver Nanoparticles (AgNP) Confined to Mesostructured, Silica-Based Calcium Phosphate against Methicillin-Resistant Staphylococcus aureus (MRSA)
Abstract
1. Introduction
2. Materials and Methods
2.1. Materials Preparation
2.2. Textural Characterization
2.3. In Vitro Bioactivity
2.4. Ag/80S Bioactive Ceramic Powders Characterization
2.5. Bacterial Incubation and Antibacterial Activity
2.5.1. Disc Diffusion Method
2.5.2. Kinetics of Microbial Growth
2.5.3. Colony-Forming Capacity Assay
3. Results
3.1. Textural Characterization of the Ag/80S Bioactive Ceramic Powders
3.2. Phase Compositions and In Vitro Bioactivity of Ag/80S Bioactive Ceramic Powders
3.3. Characterization of the Ag/80S Bioactive Ceramic Powders
3.4. Microbiological Assay of 80S and Ag/80S Bioactive Ceramic Powders
3.4.1. Disc Diffusion Method Analysis
3.4.2. Kinetics of Microbial Growth Analysis and Colony-Forming Capacity Assay Analysis
4. Discussion
5. Conclusions
Author Contributions
Funding
Acknowledgments
Conflicts of Interest
References
- The World Health Organization. The World Health Report 2007: A Safer Future: Global Public Health Security in the 21st Century; WHO: Geneva, Switzerland, 2007; pp. 1–96. Available online: https://www.who.int/whr/2007/whr07_en.pdf?ua=1 (accessed on 1 May 2020).
- Haque, M.; Sartelli, M.; McKimm, J.; Bakar, M.A. Health care-associated infections—An overview. Infect. Drug Resist. 2018, 11, 2321–2333. [Google Scholar] [CrossRef] [PubMed]
- Tong, Y.C.; Davis, J.S.; Eichenberger, E.; Holland, T.L.; Fowler, V. GStaphylococcus aureus Infections: Epidemiology, Pathophysiology, Clinical Manifestations, and Management. Clin. Microbiol. Rev. 2015, 28, 604–660. [Google Scholar] [CrossRef] [PubMed]
- Mohamed, M.F.; Abdelkhalek, A.; Seleem, M.N. Evaluation of short synthetic antimicrobial peptides for treatment of drug-resistant and intracellular Staphylococcus aureus. Sci. Rep. 2016, 6, 1–14. [Google Scholar] [CrossRef] [PubMed]
- Peterson, E.; Kaur, P. Antibiotic resistance mechanisms in bacteria: Relationships between resistance determinants of antibiotic producers, environmental bacteria, and clinical pathogens. Front. Microbiol. 2018, 9, 1–21. [Google Scholar] [CrossRef] [PubMed]
- Rizzello, L.; Pompa, P.P. Nano. Silver-based antibacterial drugs and devices: Mechanisms, methodological drawbacks, and guidelines. Chem. Soc. Rev. 2014, 43, 1501–1518. [Google Scholar] [CrossRef]
- Rai, M.K.; Deshmukh, S.D.; Ingle, A.P.; Gade, A.K. Silver nanoparticles: The powerful nanoweapon against multidrug-resistant bacteria. J. Appl. Microbiol. 2012, 112, 841–852. [Google Scholar] [CrossRef]
- Kvítek, L.; Panacek, A.; Prucek, R.; Soukupova, J.; Vanickova, M.; Kolar, M.; Zboril, R. Antibacterial activity and toxicity of silver–nanosilver versus ionic silver. J. Phys. Conf. Ser. 2011, 304, 012029. [Google Scholar] [CrossRef]
- Panáček, A.; Kvitek, L.; Prucek, R.; Kolář, M.; Večeřová, R.; Pizúrová, N.; Zbořil, R. Silver colloid nanoparticles: Synthesis, characterization, and their antibacterial activity. J. Phys. Chem. B 2006, 110, 16248–16253. [Google Scholar] [CrossRef]
- Rai, M.; Yadav, A.; Gade, A. Silver nanoparticles as a new generation of antimicrobials. Biotechnol. Adv. 2009, 27, 76–83. [Google Scholar] [CrossRef]
- Ayala-Núñez, N.V.; Villegas, H.H.L.; Turrent, L.D.C.I.; Padilla, C.R. Silver nanoparticles toxicity and bactericidal effect against methicillin-resistant Staphylococcus aureus: Nanoscale does matter. Nanobiotechnology 2009, 5, 2–9. [Google Scholar] [CrossRef]
- Lara, H.H.; Ayala-Núñez, N.V.; Turrent, L.D.C.I.; Padilla, C.R. Bactericidal effect of silver nanoparticles against multidrug-resistant bacteria. World J. Microbiol. Biotechnol. 2010, 26, 615–621. [Google Scholar] [CrossRef]
- Alt, V.; Bechert, T.; Steinrücke, P.; Wagener, M.; Seidel, P.; Dingeldein, E.; Schnettler, R. An in vitro assessment of the antibacterial properties and cytotoxicity of nanoparticulate silver bone cement. Biomaterials 2004, 25, 4383–4391. [Google Scholar] [CrossRef] [PubMed]
- Morones, J.R.; Elechiguerra, J.L.; Camacho, A.; Holt, K.; Kouri, J.B.; Ramírez, J.T.; Yacaman, M.J. The bactericidal effect of silver nanoparticles. Nanotechnology 2005, 16, 2346–2353. [Google Scholar] [CrossRef] [PubMed]
- Maneerung, T.; Tokura, S.; Rujiravanit, R. Impregnation of silver nanoparticles into bacterial cellulose for antimicrobial wound dressing. Carbohydr. Polym. 2008, 72, 43–51. [Google Scholar] [CrossRef]
- Liong, M.; France, B.; Bradley, K.A.; Zink, J.I. Antimicrobial Activity of Silver Nanocrystals Encapsulated in Mesoporous Silica Nanoparticles. Adv. Mater. 2009, 21, 1684–1689. [Google Scholar] [CrossRef]
- Yang, G.; Xie, J.; Hong, F.; Cao, Z.; Yang, X. Antimicrobial activity of silver nanoparticle impregnated bacterial cellulose membrane: Effect of fermentation carbon sources of bacterial cellulose. Carbohydr. Polym. 2012, 87, 839–845. [Google Scholar] [CrossRef]
- AshaRani, P.V.; Mun, G.L.K.; Hande, M.P.; Valiyaveettil, S. Cytotoxicity and Genotoxicity of Silver Nanoparticles in Human Cells. AES Nano 2009, 3, 279–290. [Google Scholar] [CrossRef]
- Samberg, M.E.; Oldenburg, S.J.; Monteiro-Riviere, N.A. Evaluation of Silver Nanoparticle Toxicity in Skin in Vivo and Keratinocytes in Vitro. Environ. Health Perspect. 2010, 118, 407–413. [Google Scholar] [CrossRef]
- Bellantone, M.; Coleman, N.J.; Hench, L.L. Bacteriostatic action of a novel four-component bioactive glass. J. Biomed. Mater. Res. 2000, 51, 484–490. [Google Scholar] [CrossRef]
- Bellantone, M.; Williams, H.D.; Hench, L.L. Broad-Spectrum Bactericidal Activity of Ag2O-Doped Bioactive Ceramic. Antimicrob. Agents Chemother. 2002, 46, 1940–1945. [Google Scholar] [CrossRef]
- El-Kady, A.M.; Ali, A.F.; Rizk, R.A.; Ahmed, M.M. Synthesis, Characterization and microbiological response of silver doped bioactive ceramic nanoparticles. Ceram. Int. 2012, 38, 177–188. [Google Scholar] [CrossRef]
- Phetnin, R.; Rattanachan, S.T. Preparation and antibacterial property on silver incorporated mesoporous bioactive ceramic microspheres. J. Sol-Gel Sci. Technol. 2015, 75, 279–290. [Google Scholar] [CrossRef]
- Brinker, C.J.; Lu, Y.; Sellinger, A.; Fan, H. Evaporation-induced self-assembly: Nanostructures made easy. Adv. Mater. 1999, 11, 579–585. [Google Scholar] [CrossRef]
- Jean, B.P.; Franklin, R.C.; Patricia, A.B.; George, M.E.; Janet, A.H.; Stephen, G.J.; James, S.L.; Brandi, L.; Linda, A.M.; David, P.N.; et al. Methods for Dilution Antimicrobial Susceptibility Tests for Bacteria That Grow Aerobically; Approved Standard-Tenth Edition; CLSI (NCCLS): Wayne, PA, USA, 2015; Volume 35, ISBN 1-56238-988-2. [Google Scholar]
- Ami, R.; Amini, C.T.; Nukavarapu, S.P. Bone Tissue Engineering: Recent Advances and Challenges. Crit. Rev. Biomed. Eng. 2012, 40, 363–408. [Google Scholar] [CrossRef] [PubMed]
- Kawashita, M.; Tsuneyama, S.; Miyaji, F.; Kokubo, T.; Kozuka, H.; Yamamoto, K. Antibacterial silver-containing silica ceramic prepared by sol-gel method. Biomaterials 2000, 21, 393–398. [Google Scholar] [CrossRef]
- Balamurugan, A.; Balossier, G.; Laurent-Maquin, D.; Pina, S.; Rebelo, A.H.S.; Faure, J.; Ferreira, J.M.F. An in vitro biological and anti-bacterial study on a sol–gel derived silver-incorporated bioceramic system. Dent. Mater. 2008, 24, 1343–1351. [Google Scholar] [CrossRef]
- Andrews, J.M. Determination of minimum inhibitory concentrations. J. Antimicrob. Chemother. 2001, 48 (Suppl. 1), 5–16. [Google Scholar] [CrossRef]
- Gargiulo, N.; Cusano, A.M.; Causa, F.; Caputo, D.; Netti, P.A. Silver-containing mesoporous bioactive ceramic with improved antibacterial properties. J. Mater. Sci. Mater. Med. 2013, 24, 2129–2135. [Google Scholar] [CrossRef] [PubMed]
- Peng, S.; McMahon, J.M.; Schatz, G.C.; Gray, S.K.; Sun, Y. Reversing the size-dependence of surface plasmon resonances. Proc. Natl. Acad. Sci. USA 2010, 107, 14530–14534. [Google Scholar] [CrossRef]
- Qing, Y.A.; Cheng, L.; Li, R.Y.; Liu, G.C.; Zhang, Y.B.; Tang, X.F.; Wang, J.C.; Liu, H.; Qin, Y.G. Potential antibacterial mechanism of silver nanoparticles and the optimization of orthopedic implants by advanced modification technologies. Int. J. Nanomed. 2018, 13, 3311–3327. [Google Scholar] [CrossRef]
- Khalandi, B.; Asadi, N.; Milani, M.; Davaran, S.; Abadi, A.J.N.; Abasi, E.; Akbarzadeh, A. A Review on Potential Role of Silver Nanoparticles and Possible Mechanisms of their Actions on Bacteria. Drug Res. 2017, 67, 70–76. [Google Scholar] [CrossRef] [PubMed]
- Kuo, S.H.; Chien, C.S.; Wang, C.C.; Shih, C.J. Antibacterial Activity of BSA-Capped Gold Nanoclusters against Methicillin-Resistant Staphylococcus aureus (MRSA) and Vancomycin-Intermediate Staphylococcus aureus (VISA). J. Nanomater. 2019, 2019, 4101293. [Google Scholar] [CrossRef]

| Surface Area (m2/g) | Pore Volume (cm3/g) | Mean Pore Size (nm) | |
|---|---|---|---|
| 80S | 348.9 | 0.72 | 7.3 |
| Ag1/80S | 307.6 | 0.60 | 7.5 |
| Ag10/80S | 264.5 | 0.41 | 6.2 |
© 2020 by the authors. Licensee MDPI, Basel, Switzerland. This article is an open access article distributed under the terms and conditions of the Creative Commons Attribution (CC BY) license (http://creativecommons.org/licenses/by/4.0/).
Share and Cite
Kung, J.-C.; Wang, W.-H.; Lee, C.-L.; Hsieh, H.-C.; Shih, C.-J. Antibacterial Activity of Silver Nanoparticles (AgNP) Confined to Mesostructured, Silica-Based Calcium Phosphate against Methicillin-Resistant Staphylococcus aureus (MRSA). Nanomaterials 2020, 10, 1264. https://doi.org/10.3390/nano10071264
Kung J-C, Wang W-H, Lee C-L, Hsieh H-C, Shih C-J. Antibacterial Activity of Silver Nanoparticles (AgNP) Confined to Mesostructured, Silica-Based Calcium Phosphate against Methicillin-Resistant Staphylococcus aureus (MRSA). Nanomaterials. 2020; 10(7):1264. https://doi.org/10.3390/nano10071264
Chicago/Turabian StyleKung, Jung-Chang, Wei-Hsun Wang, Chung-Lin Lee, Hao-Che Hsieh, and Chi-Jen Shih. 2020. "Antibacterial Activity of Silver Nanoparticles (AgNP) Confined to Mesostructured, Silica-Based Calcium Phosphate against Methicillin-Resistant Staphylococcus aureus (MRSA)" Nanomaterials 10, no. 7: 1264. https://doi.org/10.3390/nano10071264
APA StyleKung, J.-C., Wang, W.-H., Lee, C.-L., Hsieh, H.-C., & Shih, C.-J. (2020). Antibacterial Activity of Silver Nanoparticles (AgNP) Confined to Mesostructured, Silica-Based Calcium Phosphate against Methicillin-Resistant Staphylococcus aureus (MRSA). Nanomaterials, 10(7), 1264. https://doi.org/10.3390/nano10071264

